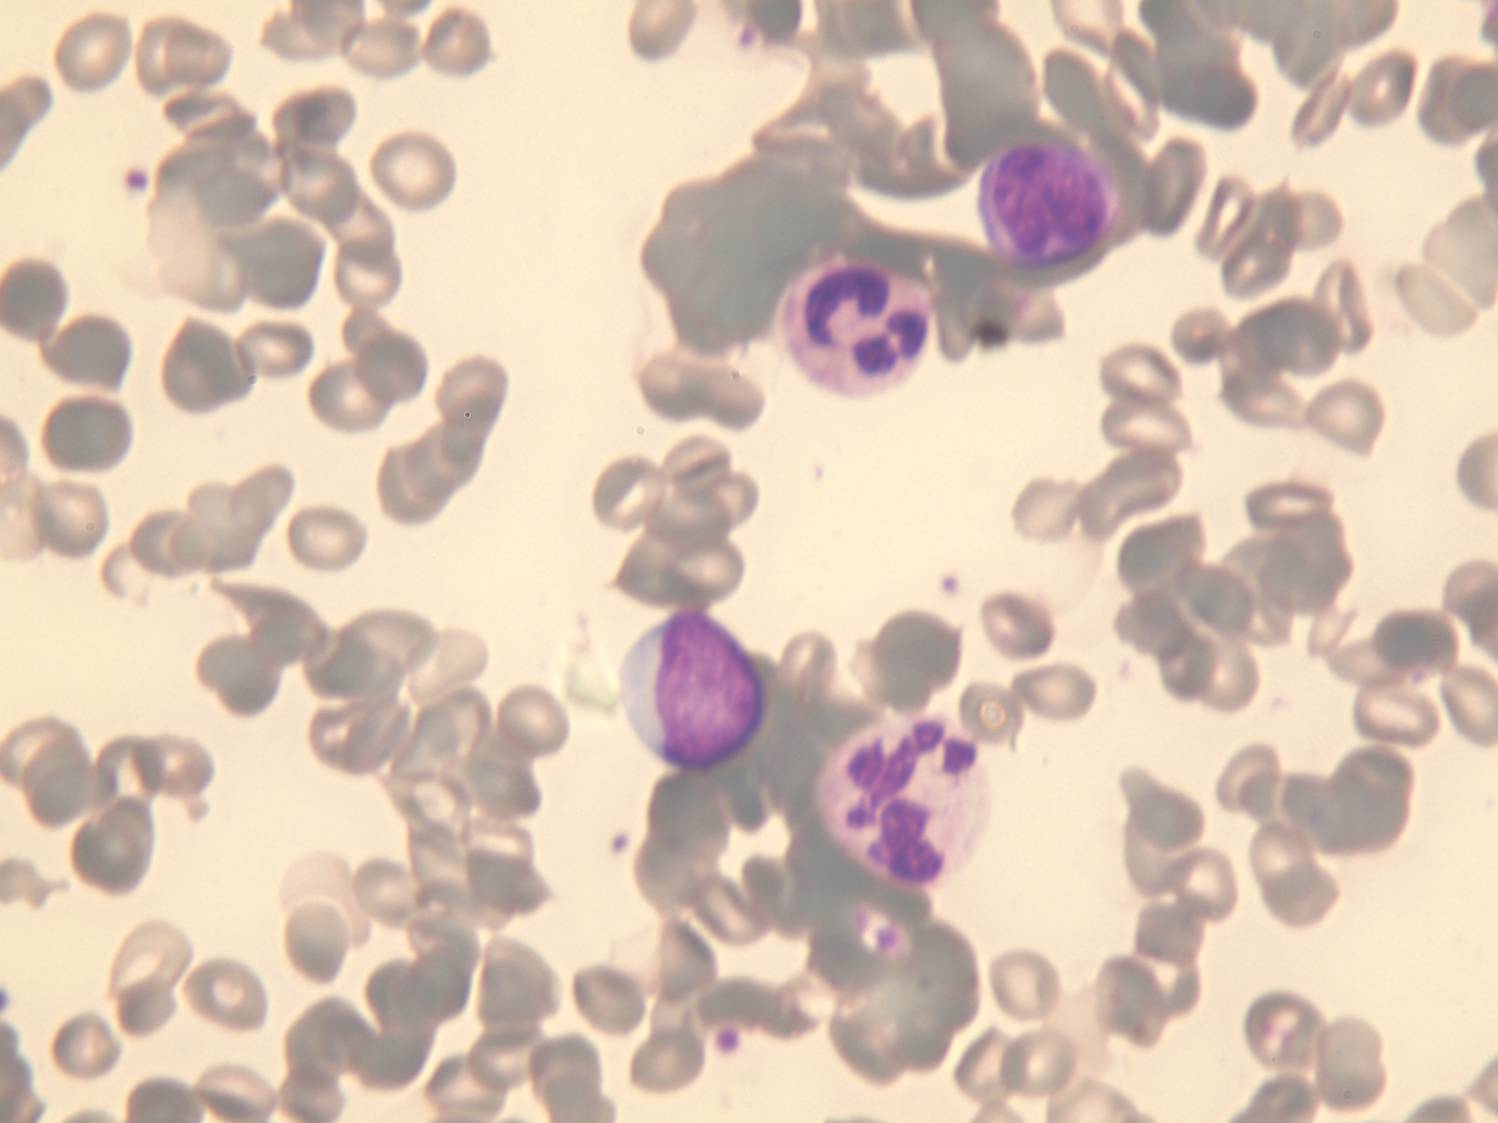

دانشکده پزشکی>گروه آموزشی خون شناسی>معرفي بيمارCase report-1CBC بیماری 23 ساله با مشخصات زیر به آزمایشگاه ارسال شده است. نکات غیر طبیعی CBC کدام است ؟در ادامه نماهایی از اسمیر خون بیمار رامشاهده می کنید . تشخیص شما چیست؟برای رفع خطاهای CBC چه راه حلی را پیشنهاد می نمایید ؟
- بازدید: 1239